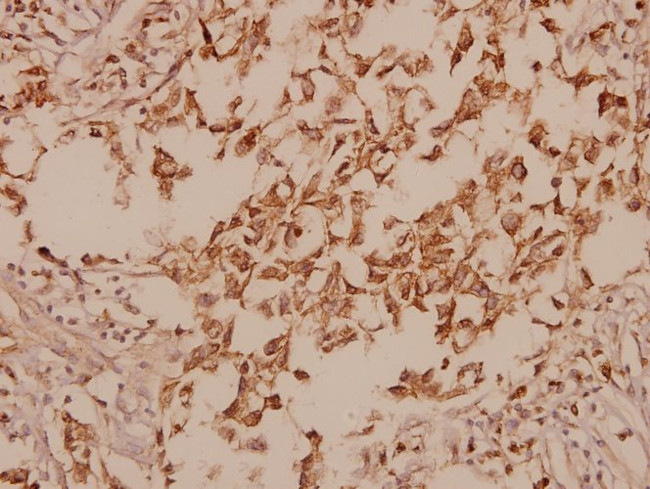
GAD67 Antibody in Immunohistochemistry (Paraffin) (IHC (P))

Search
Invitrogen
GAD67 Polyclonal Antibody
{{$productOrderCtrl.translations['antibody.pdp.commerceCard.promotion.promotions']}}
{{$productOrderCtrl.translations['antibody.pdp.commerceCard.promotion.viewpromo']}}
{{$productOrderCtrl.translations['antibody.pdp.commerceCard.promotion.promocode']}}: {{promo.promoCode}} {{promo.promoTitle}} {{promo.promoDescription}}. {{$productOrderCtrl.translations['antibody.pdp.commerceCard.promotion.learnmore']}}
产品信息
PA5-86144
宿主/亚型
分类
类型
抗原
偶联物
形式
浓度
规格
保存条件
运输条件
RRID
靶标信息
GAD-65 and GAD-67 are members of the group II decarboxylase family of proteins and are responsible for catalyzing the rate limiting step in the production of GABA (gamma-aminobutyric acid) from L-glutamic acid. Although both GADs are found in the brain, GAD-65 localizes to synaptic vesicle membranes in nerve terminals, while GAD-67 is distributed throughout the cell. GAD-67 is responsible for the basal levels of GABA synthesis. In the case of a heightened demand for GABA in neurotransmission, GAD-65 will transiently activate to assist in GABA production. The loss of GAD-65 is detrimental and can impair GABA neurotransmission, however the loss of GAD-67 is lethal. Due to alternative splicing, two isoforms exist for GAD-67: the predominant GAD-67 form and the minor GAD-25 form.
仅用于科研。不用于诊断过程。未经明确授权不得转售。